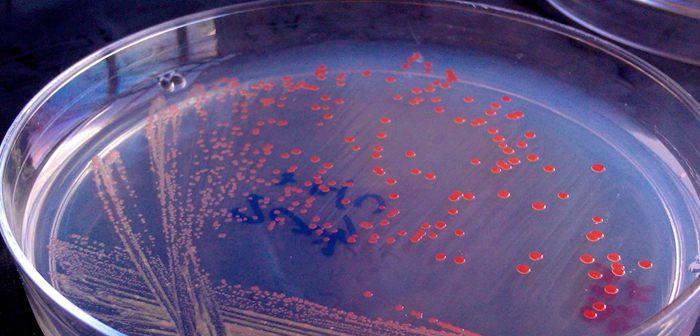
KnipBio es la primera empresa que consigue cultivar bacterias productoras de carotenoides (esenciales para el crecimiento de los pescados) y obtener acreditación comercial en EE. UU. Sin embargo siguen recibiendo críticas acerca del posible escape de cepas modificadas genéticamente.

Para luchar contra el cambio climático, el colapso de los ecosistemas, la extinción del antropóceno, la crisis del plástico y otros desafíos que la humanidad enfrenta durante este siglo, es necesario transformar todos los ámbitos donde nuestra especie tiene impacto, para paliar las consecuencias de nuestras necesidades.
La industria alimentaria y el sector restauración verán profundos cambios en las próximas décadas, desde el modo de operación hasta los productos con los que se trabaja.
En este último aspecto la biología sintética está haciendo grandes avances. Ya hemos visto que es posible popularizar una hamburguesa vegana hecha a partir de leghemoglobina de soja, pero… ¿Qué otros desarrollos están teniendo lugar en este campo en este preciso momento?

La biología sintética es un campo de la ingeniería genética que pretende dotar a organismos vivos con cualidades de interés para la sociedad. Aunque tradicionalmente relegada a la medicina e industria farmacéutica, la biología sintética está cada día más entrelazada con la alimentación sostenible.
Piensos para piscifactoría con bajo impacto ambiental, saborizantes sintéticos, claras de huevo que se desvinculan de su origen animal, cultivos celulares de miofibrillas y otras novedades han llamado la atención de los inversores, que ahora subvencionan algunas start-ups dedicadas a la biología sintética con cantidades millonarias. IndieBio es una aceleradora de empresas que presenta este perfil, por ejemplo.
Por supuesto, todos estos avances no son gratuitos. El dinero es necesario, pero el tiempo y el talento científico también.
KnipBio es la primera empresa que consigue cultivar bacterias productoras de carotenoides (esenciales para el crecimiento de los pescados) y obtener acreditación comercial en EE. UU. Sin embargo siguen recibiendo críticas acerca del posible escape de cepas modificadas genéticamente.
Otro aspecto que pone en entredicho los alimentos derivados de la biología sintética es la aparición de nuevas proteínas en nuestra dieta. Esto puede derivar en el surgimiento de nuevas alergias o enfermedades desconocidas. Los controles sobre estos productos deben ser necesariamente exhaustivos.
También brotan dudas respecto al impacto social de estas nuevas industrias. Las especias naturales podrían desaparecer de nuestros menús, y con ellas el sustento de muchas pequeñas explotaciones.

Finalmente, aunque el objetivo de la biología sintética es aliviar la carga que la humanidad deposita sobre el planeta, algunas empresas del sector no está usando materias primas sostenibles para sus investigaciones, lo cual dispara todas las alertas.
Son muchos los desafíos, pero la biología sintética tiene un buen futuro en el mundo de la restauración y de la alimentación, sin duda.



